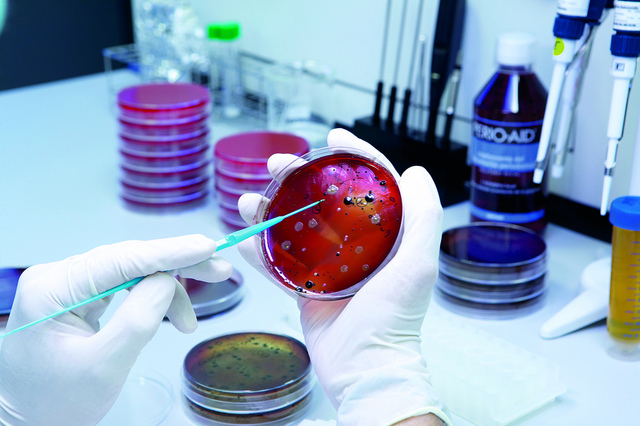
Resolución No. 826, 19 de Mayo 2003

Linea del tiempo marco legal farmacovigilancia y tecnovigilancia Wendy Mabel Vanegas Capera Bogotá D.C
-
abarca la normatividad desde 1993 hasta la fecha actual
-
Se dictan las normas para el funcionamiento de los establecimientos comerciales.
-
Se reglamenta parcialmente el régimen de vigilancia
sanitaria.
En el Artículo 146. el Invima reglamentará lo relativo a los reportes,
su contenido y periodicidad, recibirá, procesará y
analizará la información recibida, la cual será utilizada
para la definición de sus programas de vigilancia y control. -
Se reglamenta parcialmente el régimen de vigilancia
sanitaria, en Artículo 146. Se habla del reporte de información al
Invima.
El Invima reglamentará lo relativo a los reportes,
su contenido y periodicidad, recibirá, procesará y
analizará la información recibida, la cual será utilizada
para la definición de sus programas de vigilancia y control. -
Se adopta el manual de normas técnicas de calidad - guía técnica de análisis, expedido por el Instituto Nacional de Salud para efectos de control de calidad de los medicamentos, materiales medico quirúrgicos, cosméticos y productos varios.
-
Crean el comité técnico de medicamentos y se dictan normas sobre su funcionamiento, teniendo como objeto estudiar y recomendar los criterios que debe regir el proceso.
-
Se define la importancia controlada de tecnologías biomédicas, aplicadas a todas a todas las entidades públicas y privadas, personas naturales y jurídicas que conformen el sector salud.
-
Tiene como objetivo la vigilancia y el control sobre la importación, exportación, distribución y venta de materias primas de control especial y medicamentos lícitos que la contengan ya que estos crean una dependencia, y su uso inadecuado conlleva al manejo ilícito.
-
Norma que incentiva la oferta suficiente de medicamentos vitales de difícil consecución, la cual se dificulta por una baja frecuencia de su uso poca rentabilidad y tiempo de vida comercial.
-
Se establece el reglamento relativo al contenido y periodicidad de los reportes de los fabricantes de medicamentos, de que trata el articulo 146 (decreto 677)
-
Se establece el reglamento relativo al contenido y
periodicidad de los reportes de los fabricantes de
medicamentos, de que trata el artículo 146 (Decreto 677). -
se reglamenta el servicio farmacéutico
y se dictan otras disposiciones. Este decreto tiene por
objeto regular las actividades y/o procesos propios del
servicio farmacéutico entre las que se encuentra:
Participar en la creación y desarrollo de programas
relacionados con los medicamentos y dispositivos
médicos, especialmente los programas de
farmacovigilancia. -
Se reglamenta el régimen de registros sanitarios, permiso
de comercialización y vigilancia sanitaria de los dispositivos
médicos para uso humano.
El capitulo IX es bastante completo y trata acerca del
control y vigilancia de dispositivos médicos:
obligación de informar a la autoridad sanitaria cuando se tenga conocimiento de la existencia de productos alterados o fraudulentos, visitas de inspección , aplicación de las medidas sanitarias de
seguridad. -
Tiene como objetivo la vigilancia y control sobre la exportación e importación, distribución y venta de materias primas de control especial o sustancias sometidas a fiscalización, medicamentos que la contengan y las de monopolio del estado.
-
Se adopta dentro del manual de condiciones esenciales y
procedimientos del servicio farmacéutico la
farmacovigilancia. (Cap. III , numeral 5)
Se menciona sobre los programas institucionales de
farmacovigilancia, los formatos de reporte de dichos
programas, el Programa Nacional de Farmacovigilancia
y la periodicidad de los reportes. -
Se reglamenta el Programa Nacional de Tecnovigilancia.
y se definen eventos e Incidentes Adversos con Dispositivos Médicos, ( formato del reporte y contenido, ), inspección ,
vigilancia y control
Looking for a timeline maker?
Create timelines for projects, roadmaps, history, lessons, legal cases, and stories with Timetoast. Timetoast is a timeline maker for work, school, research, and stories.